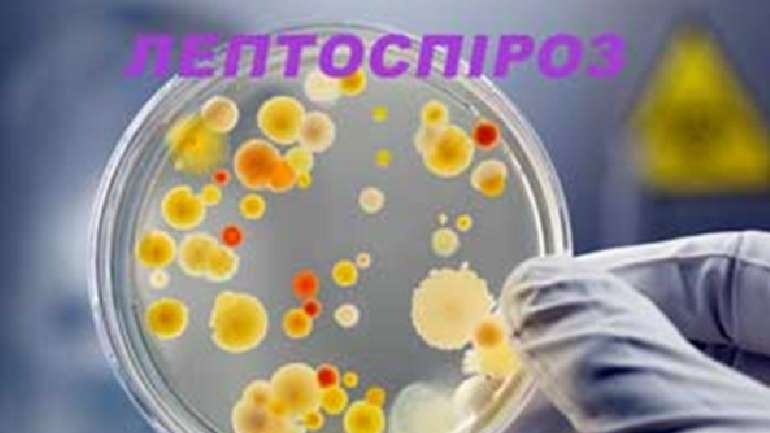

На Полтавщині виявили хвору на лептоспіроз людину
Небезпечне інфекційне захворювання спричиняє бактерія Leptospira. Без лікування лептоспіроз може призвести до ураження нирок і печінки.
Забила на сполох влада Решетилівської міської громади. Як вдалося з'ясувати, перший і поки єдиний за тривалий час випадок зараження лептоспірозом зафіксовано у Полтавському районі.
Чиновники наголошують, джерело інфекції — мишоподібні гризуни, щурі, польові миші, землерийки. Де вони, там і мікроскопічні лептоспіри, що їх тварини виділяють з сечею, а отже, потенційно заразним стає все, чого торкнувся гризун.
Своєю чергою, медики попереджають, лептоспіри зберігають життєздатність у природних водоймах від 7 до 30 днів, у вологому ґрунті від 3 до 9 місяців, у харчових продуктах — декілька днів. При підозрі на лептоспіроз лікування необхідно розпочати якнайшвидше, бо захворювання швидко прогресує.